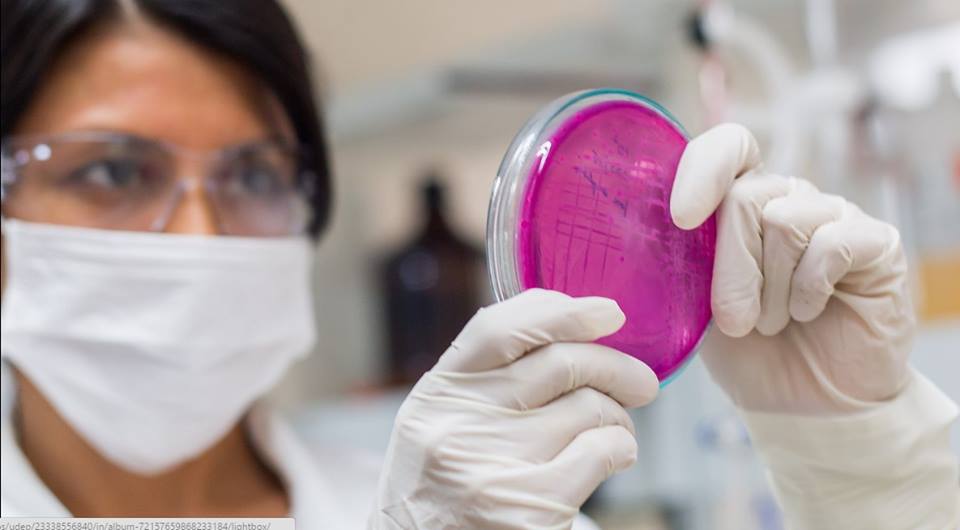

El Ministerio de la Producción (Produce) anunció la composición del Comité de Calificación que estará a cargo de evaluar y calificar las solicitudes para obtener la calificación de Centro de...
¿QUIERE LEER LA HISTORIA COMPLETA?
Regístrese y obtenga 5 artículos gratis al mes y el boletín informativo.